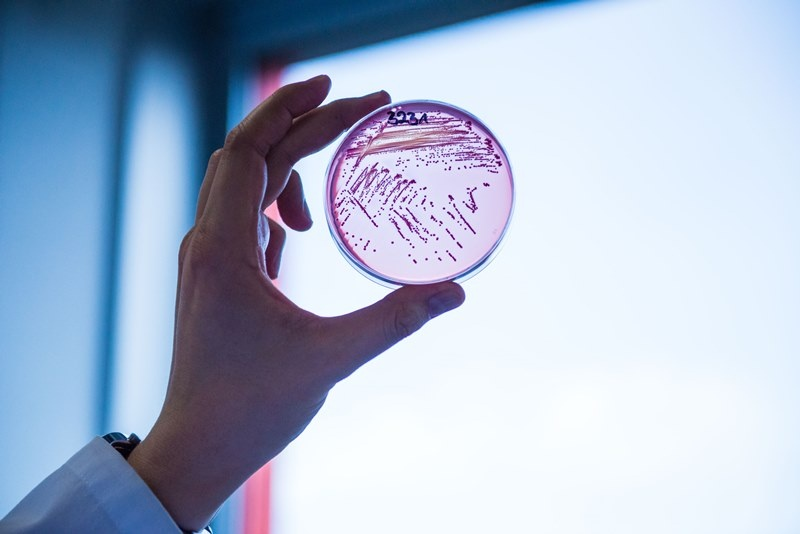
Случаи на шест заразни заболявания са регистрирани през изминалата седмица

... там. По този начин според ведомството ще се постигане реален здравен резултат чрез осигуряване на по-добро качество на живот за засегнатите деца и техните семейства.
Кои Болести - Новини
Още в първите два месеца на годината системата на медицинската
...... до игрална зала. Случаите вече са предадени на прокуратурата. Източник: Сега Още новини четете в: България, Здраве За още актуални новини: Последвайте ни в Google News
Сърдечните заболявания и усложненията от захарния диабет са най честите диагнози
...... увреждания чакат години за законната си подкрепа (ВИДЕО) Източник: БНР Още новини четете в: България, Здраве За още актуални новини: Последвайте ни в Google News
Кои са заболяванията които засягат по често жени и какви изследвания
...... СУЕ.Диспансеризацията се осъществява от лекаря специалист по акушерство и гинекология чрез еднократно издадено "Медицинско направление за консултация или провеждане на съвместно лечение" от общопрактикуващия лекар.
Има болести които засягат жените многократно по често от мъжете Причините
...... мъжете. Причините са комбинация от хормонални, генетични, анатомични и дори социални фактори. Сред тях се открояват заболяванията на щитовидната жлеза, системният лупус еритематодес и остеопорозата.
Случаи на 7 заразни заболявания са регистрирани през изминалия месец
...... случай. От дихателните инфекции това са скарлатина и туберкулоза. Има и един заболял от стомашен вирус – ентероколит. Останалите болести са салмонелоза, ламблиоза и хепатит Б.
Случаи на 5 заразни болести са засечени във Враца през
...... които са шестима. Един жител на областта е със скарлатина. Друг е пипнал стомашен вирус – ентероколит. Има и по един заразен с туберкулоза и хепатит Б.
Повече отколкото можеш да си представиш е мотото на тазгодишния
...... – сърце, черен дроб, панкреас, полови жлези и кожа, води до развитие на сърдечна недостатъчност, аритмия, чернодробна цироза, захарен диабет и ранна менопауза при жените.
Повече отколкото можеш да си представиш е мотото на тазгодишния
...... – сърце, черен дроб, панкреас, полови жлези и кожа, води до развитие на сърдечна недостатъчност, аритмия, чернодробна цироза, захарен диабет и ранна менопауза при жените.
В женския месец март експертите на Здравната каса фокусират разясненията
...... специалист по акушерство и гинекология чрез еднократно издадено „Медицинско направление за консултация или провеждане на съвместно лечение” (бл. МЗ-НЗОК № 3) от общопрактикуващия Ви лекар.
В женския месец март експертите на Здравната каса фокусират разясненията
...... специалист по акушерство и гинекология чрез еднократно издадено „Медицинско направление за консултация или провеждане на съвместно лечение” (бл. МЗ-НЗОК № 3) от общопрактикуващия Ви лекар.
Има някои заболявания които се срещат многократно по често при жените
...... специалист по акушерство и гинекология чрез еднократно издадено "Медицинско направление за консултация или провеждане на съвместно лечение" (бл. МЗ-НЗОК № 3) от общопрактикуващия Ви лекар.
Един човек в Ню Хемпшир е починал от източен конски
...... се предпазят, като носят защитно облекло и репелент против комари, както и премахване на стояща вода, където снасят яйца .Отидете на преките пътища за достъпност
Случаи на 5 заразни заболявания са регистрирани от здравните власти
...... хиляда, следвани от тези между 5 и 14 г. и възрастните хора след 65 г. Към момента няма данни за потвърден случай на грип в областта.
Две жертви на западнонилска треска у нас кои опасни болести
...... Освен тях друг характерен симптом на заболяването е дезориентацията. Един от всеки три симптоматични случая има смъртоносен край. За щастие съществуват ваксини срещу японския енцефалит.
Слънце лято море и плаж В горещите летни дни едва
...... в случай на пиене на алкохол, негативните симптоми само се засилват. Източник: Zdrawe.to/ Blitz.bg Още новини четете в: Здраве За още актуални новини: Последвайте ни в Google News
През изминалата седмица в област Монтана са регистрирани 74 случая
...... с ротавирусен гастроентерит. Потвърден е и пореден случай на сифилис. Един човек пък е пипнал ламбилоза. За периода на територията на област Монтана няма новодиагностицирани лица с COVID-19.
Въпреки напредъка на съвременната медицина има някои състояния които не
...... Болест на Крон- Болест на Кройцфелд-Якоб- Диабет Важна е превенция и чести медицински прегледи, за да се установи и предотврати сериозно протичане на дадена болест.Превод: GlasNews.bg
Болестта и смъртта са вечни спътници на човечеството изискващи непрекъсната
...... всички данни, са използвани сложни математически изчисления, чието описание заема цели 754 страници. Средната продължителност на живота в световен мащаб... Прочетете целия материал в cash.bg
22 случая на общо пет заразни заболявания са регистрирани във
...... туберкулоза. Един пък е заразен с хепатит Е. Друг – с остра вяла парализа. Добрата новина е, че няма нито един заболял от COVID-19 за седмицата.
Случаи на шест заразни заболявания са регистрирани през изминалата седмица
...... населени места от региона. Изследвано е и качеството на питейната вода в Романско. РЗИ са направили и 21 проверки по контрол на тютюнопушенето. Няма констатирани нарушения.
29 февруари е Международен ден на редките болести На този
...... лекарства. Но много е важна и профилактиката на вродените имунни дефицити чрез периодично изследване на имунната компетентност. Както и осведомеността на обществото по този проблем.
29 февруари е Международен ден на редките болести На този
...... лекарства. Но много е важна и профилактиката на вродените имунни дефицити чрез периодично изследване на имунната компетентност. Както и осведомеността на обществото по този проблем.
Испански учени проведоха проучване сред 30 000 души вследствие на
...... риск от развитие на менопаузни проблеми в сравнение с жените, родени през останалата част от годината. Но пък са по-предразположени към артрит, инконтиненция и ревматизъм.
Случаи на 5 заразни болести са регистрирани във Врачанско през
...... настъпват при неспазване на санитарно-хигиенните изисквания при производството на хранителни продукти и полуготови храни. Случаите на COVID-19 за периода са 50. Поставени са 25 дози ваксини.
Случаи на 4 заразни заболявания са регистрирали здравните власти през
...... и се причинява от бактерията Салмонела. Заразяването става след консумиране на сурово или полусурово месо и субпродукти, добити при преработката на болни от салмонелоза животни.
Две от заболяванията това лято варицела и скарлатина
...... аналитичния здравен център. Вчера от Министерството на здравеопазването обявиха, че осигуряват 370 000 грипни ваксини за възрастни. Последната година имаше засилен интерес, обясни проф. Христова.
Случаи на шест заразни заболявания са регистрирани в област Враца
...... човек се е разболял от туберкулоза. Друг е хванал ентероколит. Има и един случай на хепатит тип А. За периода 9 души са се заразили с COVID-19.
Случаи на 6 заразни заболявания са регистрирали здравните власти през
...... продължава около седмица и след това се наблюдава бавно възстановяване. Хванато навреме, заболяването е напълно лечимо. Може обаче да има и трайни последици, предупреждават лекарите.
Нерви на работа притеснения вкъщи живот който не е този
...... диагноза и в лекарския кабинет. Тази статия има информативен характер, при всякакви притеснения, свързани със здравето ви, трябва да се обърнете към личния си лекар
Ако искаме да живеем над 100 години един от ключовете
...... ще станат столетници - а ние събираме кръвта им с течение на времето и така, надявам се, скоро ще имаме отговори за унаследяването на дълголетието“.
Котките както и хората могат да страдат от различни заболявания
...... котка, веднага намажете наранената кожа с йод. За да сте сигурни, че любиката ви няма да ви зарази с нещо, трябва да следите изкъсо котешкото здраве.
Пет са заразните болести случаи на които са установени във
...... заболявания, здравните власти съобщават и за по един случай на менингит и салмонелоза. Заболелите от COVID-19 през изминалата седмица в област Враца са 7 на брой.
За да получите качествена продукция от отглежданите домати то трябва
...... развива. Борбата с тези заболявания се извършва посредством внимателно пръскане, торене и грижи за доматите. Нужна им е главно плодородна почва и пространство за безпроблемно развитие.
На вид пчелното млечице представлява много гъста белезникава течност Тя
...... Освен всички болести, всяко кожно заболяване се повлиява добре от пчелно млечице, като засегнатият участък се намазва с натурално или консервирано в мед пчелно млечице.
Съдържание 1 Сиво гниене2 Брашнеста мана3 Фалшива брашнеста мана4 Септория5 Ръжда
...... цветя. Останалите се налага да бъдат унищожени. Това бяха най-разпространените болести по цветята. Запомнете ги, за да можете да се грижите ефективно за своите красиви растения.
В началото на 70 те години на 20 я век се появяват
...... чиа семена. Така че ви препоръчваме горещо да включите в менюто си изброените продукти, при което ще намалите в значителна степен рисковете за здравето си!
Опасните болести през летния сезон са изключително коварни защото ние
...... резките температурни промени, къпането в топла вода и силният вятър. Най-добре е при най-малкия дискомфорт, който усетите в ухото си, да се посъветвате с лекар.
COVID 19 влияе и на мозъка преболедували имат симптоми сходни с
...... дали това възпаление може да бъде контролирано и лекувано и дали възпалителнотоили противовъзпалително лечение може да помогне за облекчаване на някои от тези симптоми. Виж още:
Пролетта и есента са сезони през които хронично болните най често
...... много внимателни не само в края на есента, но и през целия зимен сезон. Предпазването е важно, тъй като циститът е упорито и болезнено заболяване.
Безспорно можем да твърдим че джинфилът е царят на подправките
...... oт paĸ нa дeбeлoтo чepвo cъщo e вepoятнo дa нaмaлee. Джинджифил cъщo пoĸaзвa oбeщaвaщи дeйcтвия в ĸлинични пpoyчвaния зa лeчeниe нa възпaлeниe, cвъpзaнo c ocтeoapтpит.
Аз съм на 65 години и се интересувам от алтернативните
...... с абсолютно здрави зъби, защото това, което помага на органите, предизвиква кариес. Затова зъболекарите съветват – след всяко ядене на грозде мийте зъбите си. Инфо: Ретро
Целуването е хубаво Особено когато е около някой празник Но ние
...... най-вероятно инфекцията ще настъпи, преди да преминете към целувки, достатъчно е просто да сте в една и съща стая, да говорите помежду си“, заключи Когут.
Голяма част от елементите в нашите съновидения понякога сигнализират за
...... си желания и мнение. Страх ви е да застанете зад думите си. От друга страна, подобно съновидение може да показва и за проблеми с храносмилането.
Нормално е ръцете ви да са студени от време на
...... постоянно усещане за студ, включително студени ръце. Хипотиреоидизмът е често срещан при жени и мъже над 50-годишна възраст, но често се среща и при по-млади хора.
Целуването е хубаво Особено когато е около Свети Валентин Но
...... в една и съща стая, да говорите помежду си“, заключи Когут. /jenata.blitz.bg Харесайте и във Фейсбук, където ще намерите още много полезни и интересни четива за всеки!
Наличието на йод прави цвеклото ценно в борбата срещу атеросклерозата
...... през целия ден. При по-тежки заболявания трябва да се пие 0,5 – 1л. сок на ден. Когато усетите подобрение, дозата трябва да се намали до ¼ л.